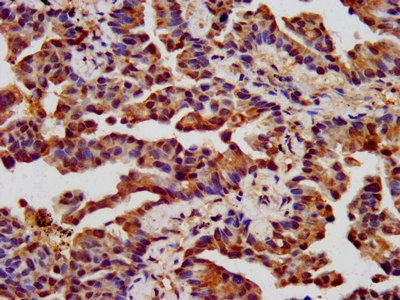

CHRNB3 Antibody
-
中文名稱:CHRNB3兔多克隆抗體
-
貨號:CSB-PA005397LA01HU
-
規格:¥440
-
圖片:
-
Western Blot
Positive WB detected in: Mouse liver tissue
All lanes: CHRNB3 antibody at 5.1μg/ml
Secondary
Goat polyclonal to rabbit IgG at 1/50000 dilution
Predicted band size: 53 kDa
Observed band size: 53 kDa -
IHC image of CSB-PA005397LA01HU diluted at 1:400 and staining in paraffin-embedded human lung cancer performed on a Leica BondTM system. After dewaxing and hydration, antigen retrieval was mediated by high pressure in a citrate buffer (pH 6.0). Section was blocked with 10% normal goat serum 30min at RT. Then primary antibody (1% BSA) was incubated at 4°C overnight. The primary is detected by a biotinylated secondary antibody and visualized using an HRP conjugated SP system.
-
IHC image of CSB-PA005397LA01HU diluted at 1:400 and staining in paraffin-embedded human endometrial cancer performed on a Leica BondTM system. After dewaxing and hydration, antigen retrieval was mediated by high pressure in a citrate buffer (pH 6.0). Section was blocked with 10% normal goat serum 30min at RT. Then primary antibody (1% BSA) was incubated at 4°C overnight. The primary is detected by a biotinylated secondary antibody and visualized using an HRP conjugated SP system.
-
Immunofluorescence staining of Hela cells with CSB-PA005397LA01HU at 1:133, counter-stained with DAPI. The cells were fixed in 4% formaldehyde, permeabilized using 0.2% Triton X-100 and blocked in 10% normal Goat Serum. The cells were then incubated with the antibody overnight at 4°C. The secondary antibody was Alexa Fluor 488-congugated AffiniPure Goat Anti-Rabbit IgG(H+L).
-
-
其他:
產品詳情
-
產品名稱:Rabbit anti-Homo sapiens (Human) CHRNB3 Polyclonal antibody
-
Uniprot No.:
-
基因名:CHRNB3
-
別名:CHRNB3 antibody; Neuronal acetylcholine receptor subunit beta-3 antibody
-
宿主:Rabbit
-
反應種屬:Human, Mouse
-
免疫原:Recombinant Human Neuronal acetylcholine receptor subunit beta-3 protein (67-218AA)
-
免疫原種屬:Homo sapiens (Human)
-
標記方式:Non-conjugated
本頁面中的產品,CHRNB3 Antibody (CSB-PA005397LA01HU),的標記方式是Non-conjugated。對于CHRNB3 Antibody,我們還提供其他標記。見下表:
-
克隆類型:Polyclonal
-
抗體亞型:IgG
-
純化方式:>95%, Protein G purified
-
濃度:It differs from different batches. Please contact us to confirm it.
-
保存緩沖液:Preservative: 0.03% Proclin 300
Constituents: 50% Glycerol, 0.01M PBS, pH 7.4 -
產品提供形式:Liquid
-
應用范圍:ELISA, WB, IHC, IF
-
推薦稀釋比:
Application Recommended Dilution WB 1:500-1:5000 IHC 1:200-1:500 IF 1:50-1:200 -
Protocols:
-
儲存條件:Upon receipt, store at -20°C or -80°C. Avoid repeated freeze.
-
貨期:Basically, we can dispatch the products out in 1-3 working days after receiving your orders. Delivery time maybe differs from different purchasing way or location, please kindly consult your local distributors for specific delivery time.
-
用途:For Research Use Only. Not for use in diagnostic or therapeutic procedures.
相關產品
靶點詳情
-
功能:After binding acetylcholine, the AChR responds by an extensive change in conformation that affects all subunits and leads to opening of an ion-conducting channel across the plasma membrane.
-
基因功能參考文獻:
- To gain a better understanding of the pathological processes underlying ND and ND-related behaviors and to promote the development of effective smoking cessation therapies, we here present the most recent studies concerning the genetic effects of the CHRNB3-CHRNA6 gene cluster in ND. PMID: 27327258
- More low frequency variants in the CHRNA6/CHRNB3 gene region were observed in cases compared to controls. PMID: 27085880
- Data provide evidence that the protective genetic variant at rs6474413 identified in human genetic studies reduces gene expression and that decreased beta3 gene expression in mice reduces nicotine intake PMID: 26318101
- This patient's chromosomal abnormality affected only one gene that is highly expressed in the brainstem and brain, involved in neurotransmission, and could be related to her Duane retraction syndrome. PMID: 24001015
- the CHRNB3-A6 locus contains multiple variants affecting risk for vulnerability to cocaine and nicotine dependence as well as bipolar disorder, suggesting that they have pleiotropic effects. PMID: 24675634
- Polymorphism in CHRNB3 gene is associated with esophageal adenocarcinoma. PMID: 25823894
- The common variant rs13273442 in the CHRNB3-CHNRA6 region is associated significantly with nicotine dependence in European Americans and African Americans. PMID: 24401102
- CHRNB3 c.-57A>G alteration affects the promoter activity and is associated with Parkinson's disease (PD), and smoking in PD patients. PMID: 24731518
- this study provides convincing evidence for a role of CHRNB3 in Nicotine Dependence. PMID: 23319001
- these results demonstrate that the combined effect of rs6474412-C/T polymorphism in smoking-related CHRNB3-CHRNA6 region gene and smoking behavior may not confer risk to psoriasis vulgaris (PV), but may have impact on PV severity in Chinese Han population. PMID: 24792900
- Results demonstrate the association between SNPs in CHRNB3 nicotinic acetylcholine receptor genes and the risk of smoking in ADHD PMID: 23899432
- The results indicate the genetic locus for the CHRNB3 gene is strongly associated with nicotine dependence. PMID: 22524403
- beta3 subunit coexpression promotes function of alpha6*-nAChR PMID: 22315221
- Variants in CHRNB3/CHRNA6 are independently associated with bipolar disorder. PMID: 21191315
- The GG genotype of SNP rs13261190 in the CHRNB3 was associated with increased novelty seeking in alcohol-dependent individuals. PMID: 21606657
- CHRNB3 and CHRNA6 polymorphisms are associated with smoking behavior and lung cancer susceptibility in Chinese Han population. PMID: 21831805
- Three single nucleotide polymorphisms (SNPs) in CHRNA6 and one SNP in CHRNB3 are associated with a composite of alcohol phenotypes. PMID: 19500157
- CHRNB3-CHRNA6 and CYP2A6 sequence variants affect smoking behavior PMID: 20418888
- CHRNB3 is associated with subjective responses to tobacco. PMID: 18055561
- Together these results further implicate the region downstream of CHRNA6 and the region upstream of CHRNB3 in risk of nicotine dependence. PMID: 18704094
顯示更多
收起更多
-
亞細胞定位:Cell junction, synapse, postsynaptic cell membrane; Multi-pass membrane protein. Cell membrane; Multi-pass membrane protein.
-
蛋白家族:Ligand-gated ion channel (TC 1.A.9) family, Acetylcholine receptor (TC 1.A.9.1) subfamily, Beta-3/CHRNB3 sub-subfamily
-
數據庫鏈接:
Most popular with customers
-
-
YWHAB Recombinant Monoclonal Antibody
Applications: ELISA, WB, IHC, IF, FC
Species Reactivity: Human, Mouse, Rat
-
Phospho-YAP1 (S127) Recombinant Monoclonal Antibody
Applications: ELISA, WB, IHC
Species Reactivity: Human
-
-
-
-
-